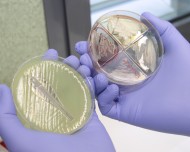

Idioma:
- Español
- Català
Busca a tu profesional
En transporte público:
EMT: Líneas 6, 20, 29, 33, 34, 36, 39
En coche:
. Por Carrer d'Aragó/Ma-13A y Ma-20
Bicipalma
https://www.bicipalma.com/es/palma/
Descargar díptico: "Cómo llegar a Son Espases"
De lunes a viernes 8h - 20h
En transporte público:
En coche: